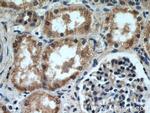
NMT1 Antibody in Immunohistochemistry (Paraffin) (IHC (P))

Search
Proteintech
NMT1 Polyclonal Antibody
{{$productOrderCtrl.translations['antibody.pdp.commerceCard.promotion.promotions']}}
{{$productOrderCtrl.translations['antibody.pdp.commerceCard.promotion.viewpromo']}}
{{$productOrderCtrl.translations['antibody.pdp.commerceCard.promotion.promocode']}}: {{promo.promoCode}} {{promo.promoTitle}} {{promo.promoDescription}}. {{$productOrderCtrl.translations['antibody.pdp.commerceCard.promotion.learnmore']}}
产品信息
11546-1-AP
种属反应
已发表种属
宿主/亚型
分类
类型
抗原
偶联物
形式
浓度
规格
纯化类型
保存液
内含物
保存条件
运输条件
产品详细信息
Immunogen sequence: MADESETAV KPPAPPLPQM MEGNGNGHEH CSDCENEEDN SYNRGGLSPA NDTGAKKKKK KQKKKKEKGS ETDSAQDQPV KMNSLPAERI QEIQKAIELF SVGQGPAKTM EEASKRSYQF WDTQPVPKLG EVVNTHGPVE PDKDNIRQEP YTLPQGFTWD ALDLGDRGVL KELYTLLNEN YVEDDDNMFR FDYSPEFLLW ALRPPGWLPQ WHCGVRVVSS RKLVGFISAI PANIHIYDTE KKMVEINFLC VHKKLRSKRV APVLIREITR RVHLEGIFQA VYTAGVVLPK PVGTCRYWHR SL (1-301 aa encoded by BC006569)
靶标信息
NMT1 is involved with Myristate, a rare 14-carbon saturated fatty acid, is cotranslationally attached by an amide linkage to the N-terminal glycine residue of cellular and viral proteins with diverse functions. N-myristoyltransferase (NMT EC 2.3.1.97) catalyzes the transfer of myristate from CoA to proteins. N-myristoylation appears to be irreversible and is required for full expression of the biologic activities of several N-myristoylated proteins, including the alpha subunit of the signal-transducing guanine nucleotide-binding protein (G protein) GO (GNAO1 MIM 139311).
仅用于科研。不用于诊断过程。未经明确授权不得转售。
生物信息学
蛋白别名: alternative, short form NMT-S; Glycylpeptide N-tetradecanoyltransferase 1; HsNMT1; long form, NMT-L; Myristoyl-CoA:protein N-myristoyltransferase 1; NMT 1; Peptide N-myristoyltransferase 1; Protein-lysine myristoyltransferase NMT1; type I N-myristoyltransferase; unnamed protein product
基因别名: AW536594; HsNMT1; NMT; NMT1
UniProt ID: (Human) P30419, (Mouse) O70310, (Rat) Q8K1Q0
Entrez Gene ID: (Human) 4836, (Mouse) 18107, (Rat) 259274